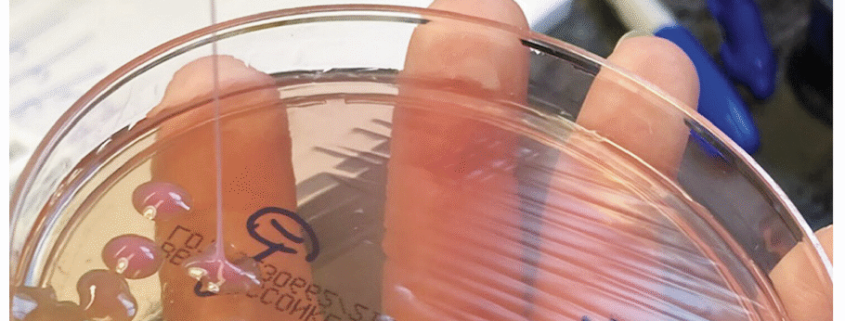
This may be the grossest eye pic ever—but the cause is what’s truly horrifying

This may be the grossest eye pic ever—but the cause is what’s truly horrifying
Hypervirulent Bacteria Wreaks Havoc on 63-Year-Old Man’s Body, Sparking Global Health Concerns
In a chilling medical case that underscores the growing threat of hypervirulent bacteria worldwide, a 63-year-old man from the New England area found himself battling a life-threatening infection that ravaged multiple organs, including his brain and eyes. What began as a seemingly ordinary case of food poisoning spiraled into a medical nightmare, leaving doctors scrambling to identify and contain the pathogen responsible.
The ordeal began three weeks before the man sought medical attention. He reported consuming spoiled meat, which led to vomiting and diarrhea. While these symptoms subsided after about two weeks, new and more alarming issues emerged. He developed a persistent cough, chills, and a high fever. His condition deteriorated rapidly, and the cough became so severe that it prompted an emergency hospital visit.
Upon arrival at the hospital, doctors conducted a series of diagnostic tests, including X-rays and computed tomography (CT) scans of his chest and abdomen. The results were shocking. The imaging revealed over 15 nodules and masses in his lungs, a clear indication of a severe infection. But the most alarming discovery was a massive 8.6 cm (3.4 inches) mass in his liver. Laboratory tests confirmed the presence of an infection, leading to his immediate admission to the hospital.
To combat the infection, doctors administered oxygen to assist with his breathing and prescribed a course of antibiotics. Despite these interventions, the man’s condition continued to worsen. His chills persisted, and his cough remained unrelenting. The medical team faced a daunting challenge: identifying the exact pathogen responsible for this devastating infection.
As the investigation progressed, doctors uncovered a grim reality. The man was infected with a hypervirulent strain of bacteria, a type of pathogen that has been on the rise globally in recent years. These bacteria are notorious for their ability to cause severe, life-threatening infections, often targeting multiple organs simultaneously. In this case, the bacteria had not only attacked his lungs and liver but had also infiltrated his brain and eyes, leading to vision problems in his right eye.
The case has sent shockwaves through the medical community, highlighting the urgent need for increased awareness and research into hypervirulent bacteria. Experts warn that these pathogens pose a significant threat to public health, particularly as they become more resistant to conventional treatments. The man’s ordeal serves as a stark reminder of the potential consequences of consuming contaminated food and the importance of food safety practices.
While the man’s condition remains critical, doctors are cautiously optimistic about his recovery. They continue to monitor his progress closely, adjusting his treatment plan as needed. The case has also sparked a broader conversation about the need for improved diagnostic tools and therapies to combat hypervirulent bacteria.
As this story unfolds, it serves as a sobering reminder of the invisible threats that lurk in our environment and the importance of vigilance in protecting our health. The medical community is now calling for increased funding and research to better understand and combat these emerging pathogens, ensuring that cases like this one become less common in the future.
Tags and Viral Phrases:
- Hypervirulent bacteria
- Life-threatening infection
- Multiple organ failure
- Food poisoning nightmare
- Global health threat
- Medical mystery
- Brain and eye infection
- Antibiotic resistance
- Public health crisis
- Food safety warning
- Emerging pathogens
- Critical condition
- Medical community alarmed
- Urgent research needed
- Invisible threats
- Vigilance in health
- Contaminated food dangers
- Diagnostic challenges
- Treatment struggles
- Recovery hopes
- Medical breakthrough needed
- Health awareness
- Pathogen resistance
- Organ damage
- Vision problems
- Chills and fever
- Persistent cough
- Hospital admission
- Oxygen therapy
- Antibiotic treatment
- Medical investigation
- Patient monitoring
- Health professionals concerned
- Community impact
- Future prevention
- Medical innovation
- Patient advocacy
- Health education
- Global implications
,

Leave a Reply
Want to join the discussion?Feel free to contribute!